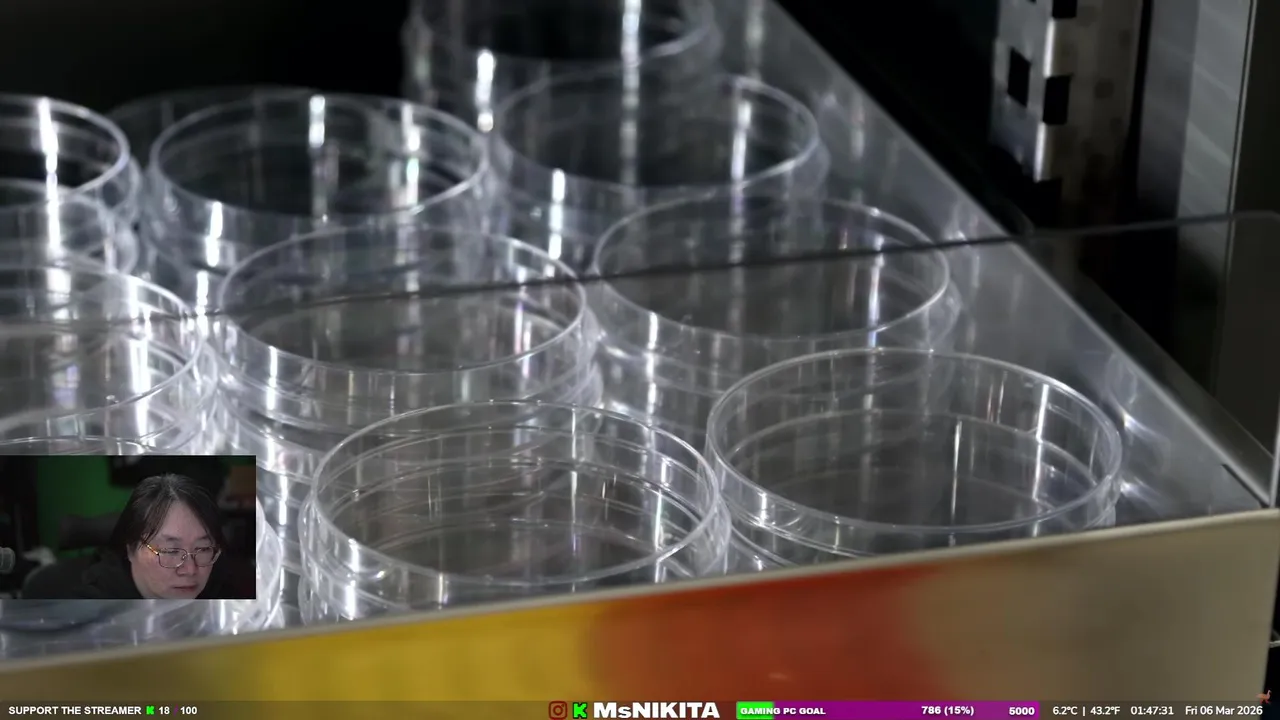

Language
-
3801
 vorterixsantarosa
on twitch.tv
vorterixsantarosa
on twitch.tv
Viewers: 8
Duration: 53 min. -
3802
 RADIOCONTACTOTV
on twitch.tv
RADIOCONTACTOTV
on twitch.tv
Viewers: 8
Duration: 103 min. -
3803
 TheLegendaryJiggs
on twitch.tv
TheLegendaryJiggs
on twitch.tv
Viewers: 8
Duration: 46 min. -
3804
 shiroo26
on twitch.tv
shiroo26
on twitch.tv
Viewers: 8
Duration: 249 min. -
3805
 JoseeVallado
on twitch.tv
JoseeVallado
on twitch.tv
Viewers: 8
Duration: 10 min. -
3806
 chimitiro
on twitch.tv
chimitiro
on twitch.tv
Viewers: 8
Duration: 89 min. -
3807
 michelpaolaa
on twitch.tv
michelpaolaa
on twitch.tv
Viewers: 8
Duration: 9 min. -
3808
 Dodooro
on twitch.tv
Dodooro
on twitch.tv
Viewers: 8
Duration: 10 min. -
3809
 Ruri_MoonVT
on twitch.tv
Ruri_MoonVT
on twitch.tv
Viewers: 8
Duration: 1 min. -
3810
 TheeCronox
on twitch.tv
TheeCronox
on twitch.tv
Viewers: 8
Duration: 13 min. -
3811
 FacuBenitez51_
on twitch.tv
FacuBenitez51_
on twitch.tv
Viewers: 8
Duration: 43 min. -
3812
 ElRisingg
on twitch.tv
ElRisingg
on twitch.tv
Viewers: 8
Duration: 10 min. -
3813
 Sugacito
on twitch.tv
Sugacito
on twitch.tv
Viewers: 8
Duration: 89 min. -
3814
 galiammx
on twitch.tv
galiammx
on twitch.tv
Viewers: 8
Duration: 60 min. -
3815
 ach_teco7
on twitch.tv
ach_teco7
on twitch.tv
Viewers: 8
Duration: 1 min. -
3816
 junexfx
on twitch.tv
junexfx
on twitch.tv
Viewers: 8
Duration: 4 min. -
3817
 BarryIsNiceNow
on twitch.tv
BarryIsNiceNow
on twitch.tv
Viewers: 8
Duration: 22 min. -
3818
 SpaceLabxxx
on twitch.tv
SpaceLabxxx
on twitch.tv
Viewers: 8
Duration: 119 min. -
3819
 AmayaSings
on twitch.tv
AmayaSings
on twitch.tv
Viewers: 8
Duration: 18 min. -
3820
 LeeToTheVideoGaming
on twitch.tv
LeeToTheVideoGaming
on twitch.tv
Viewers: 8
Duration: 28 min. -
3821
 ChrisInternational
on twitch.tv
ChrisInternational
on twitch.tv
Viewers: 8
Duration: 4 min. -
3822
 CoyoteExpress
on twitch.tv
CoyoteExpress
on twitch.tv
Viewers: 8
Duration: 212 min. -
3823
 TheLastSongwriter
on twitch.tv
TheLastSongwriter
on twitch.tv
Viewers: 8
Duration: 31 min. -
3824
 grecoweston
on twitch.tv
grecoweston
on twitch.tv
Viewers: 8
Duration: 27 min. -
3825
 sethspool
on twitch.tv
sethspool
on twitch.tv
Viewers: 8
Duration: 3 min. -
3826
 greenbullitt806
on twitch.tv
greenbullitt806
on twitch.tv
Viewers: 8
Duration: 25 min. -
3827
 llHRV
on twitch.tv
llHRV
on twitch.tv
Viewers: 8
Duration: 49 min. -
3828
♥밍이♥ on afreecatv.com
Viewers: 8
Duration: 44 min. -
3829
 hetrazidana
on twitch.tv
hetrazidana
on twitch.tv
Viewers: 8
Duration: 50 min. -
3830
 MrTsaoGaming
on twitch.tv
MrTsaoGaming
on twitch.tv
Viewers: 8
Duration: 286 min. -
3831
 もちむぎ00
on twitch.tv
もちむぎ00
on twitch.tv
Viewers: 8
Duration: 146 min. -
3832
 清水一豊と申します
on twitch.tv
清水一豊と申します
on twitch.tv
Viewers: 8
Duration: 203 min. -
3833
 SdRChannel
on twitch.tv
SdRChannel
on twitch.tv
Viewers: 8
Duration: 70 min. -
3834
 SCOO_D_TV
on twitch.tv
SCOO_D_TV
on twitch.tv
Viewers: 8
Duration: 104 min. -
3835
 Xo_Manu
on twitch.tv
Xo_Manu
on twitch.tv
Viewers: 8
Duration: 52 min. -
3836
 zhenavaska
on twitch.tv
zhenavaska
on twitch.tv
Viewers: 8
Duration: 20 min. -
3837
 ServaLtv
on twitch.tv
ServaLtv
on twitch.tv
Viewers: 8
Duration: 11 min. -
3838
 Rizik4sv
on twitch.tv
Rizik4sv
on twitch.tv
Viewers: 8
Duration: 1 min. -
3839
 chagasreality
on twitch.tv
chagasreality
on twitch.tv
Viewers: 8
Duration: 1671 min. -
3840
2윤승 on afreecatv.com
Viewers: 8
Duration: 61 min. -
3841
 xoe.warhol
on younow.com
xoe.warhol
on younow.com
Viewers: 8
Duration: 10 min. -
3842
#노채 on afreecatv.com
Viewers: 8
Duration: 57 min. -
3843
 sillybit666
on twitch.tv
sillybit666
on twitch.tv
Viewers: 8 -
3844
 melflacooo
on twitch.tv
melflacooo
on twitch.tv
Viewers: 8
Duration: 6 min. -
3845
 TheToknSquirrel
on twitch.tv
TheToknSquirrel
on twitch.tv
Viewers: 8
Duration: 813 min. -
3846
 bundave
on twitch.tv
bundave
on twitch.tv
Viewers: 8
Duration: 1281 min. -
3847
 solaceplum
on twitch.tv
solaceplum
on twitch.tv
Viewers: 8
Duration: 33 min. -
3848
 WildRizzlyBear
on twitch.tv
WildRizzlyBear
on twitch.tv
Viewers: 8
Duration: 125 min. -
3849
 Key3tone
on twitch.tv
Key3tone
on twitch.tv
Viewers: 8
Duration: 48 min. -
3850
 FinesseTheProducer
on twitch.tv
FinesseTheProducer
on twitch.tv
Viewers: 8
Duration: 3 min. -
3851
 TacticalSkillet
on twitch.tv
TacticalSkillet
on twitch.tv
Viewers: 8
Duration: 6 min. -
3852
 Nifadelic
on twitch.tv
Nifadelic
on twitch.tv
Viewers: 8
Duration: 150 min. -
3853
 DiscoveringJapan
on twitch.tv
DiscoveringJapan
on twitch.tv
Viewers: 8
Duration: 4 min. -
3854
 pl4tino_
on twitch.tv
pl4tino_
on twitch.tv
Viewers: 8
Duration: 104 min. -
3855
 PinkyPlush
on twitch.tv
PinkyPlush
on twitch.tv
Viewers: 8
Duration: 20 min. -
3856
 BreakyTime
on twitch.tv
BreakyTime
on twitch.tv
Viewers: 8
Duration: 48 min. -
3857
 tiktokpool3
on twitch.tv
tiktokpool3
on twitch.tv
Viewers: 8
Duration: 279 min. -
3858
 maaboy25
on twitch.tv
maaboy25
on twitch.tv
Viewers: 8
Duration: 3 min. -
3859
 Zavaho_lori
on twitch.tv
Zavaho_lori
on twitch.tv
Viewers: 8
Duration: 11 min. -
3860
 FedorableWill
on twitch.tv
FedorableWill
on twitch.tv
Viewers: 8
Duration: 104 min. -
3861
 MackeeMouseMedia
on twitch.tv
MackeeMouseMedia
on twitch.tv
Viewers: 8
Duration: 143 min. -
3862
 VeillyOmbreVirtual
on twitch.tv
VeillyOmbreVirtual
on twitch.tv
Viewers: 8
Duration: 158 min. -
3863
 Felipe 😎/😜
on bigo.tv
Felipe 😎/😜
on bigo.tv
Viewers: 8
Duration: 14 min. -
3864
 wlayusername
on younow.com
wlayusername
on younow.com
Viewers: 8
Duration: 23 min. -
3865
BJ유디티 on afreecatv.com
Viewers: 8
Duration: 55 min. -
3866
밀리; on afreecatv.com
Viewers: 8
Duration: 112 min. -
3867
MsNIKITA
on kick.com
MsNIKITA
on kick.com
Viewers: 8
Duration: 1 min. -
3868
 ploars
on kick.com
ploars
on kick.com
Viewers: 8
Duration: 20 min. -
3869
 🤎🧸ଘ𝓨𝓾𝓲໒꒱🧸🤎
on 17.live
🤎🧸ଘ𝓨𝓾𝓲໒꒱🧸🤎
on 17.live
Viewers: 8
Duration: 39 min. -
3870
 karycats
on twitch.tv
karycats
on twitch.tv
Viewers: 8
Duration: 7 min. -
3871
 sseb4z
on twitch.tv
sseb4z
on twitch.tv
Viewers: 8
Duration: 13 min. -
3872
 xIckizx
on twitch.tv
xIckizx
on twitch.tv
Viewers: 8
Duration: 26 min. -
3873
 gajotw
on twitch.tv
gajotw
on twitch.tv
Viewers: 8
Duration: 53 min. -
3874
 leo66868
on twitch.tv
leo66868
on twitch.tv
Viewers: 8
Duration: 47 min. -
3875
 ska_tea
on twitch.tv
ska_tea
on twitch.tv
Viewers: 8
Duration: 25 min. -
3876
 Dj_Turn
on twitch.tv
Dj_Turn
on twitch.tv
Viewers: 8
Duration: 23 min. -
3877
 i1WAFI
on twitch.tv
i1WAFI
on twitch.tv
Viewers: 8 -
3878
 bnanh
on twitch.tv
bnanh
on twitch.tv
Viewers: 8 -
3879
 zelie_nina
on twitch.tv
zelie_nina
on twitch.tv
Viewers: 8
Duration: 78 min. -
3880
 🍓Air.💚歌う農家💋
on 17.live
🍓Air.💚歌う農家💋
on 17.live
Viewers: 8
Duration: 84 min. -
3881
 DropInDropOutPod
on twitch.tv
DropInDropOutPod
on twitch.tv
Viewers: 8
Duration: 19 min. -
3882
 Lil E🍃
on liveme.com
Lil E🍃
on liveme.com
Viewers: 8 -
3883
 健一💟💘💙ྀི913🐶🐠🦐
on 17.live
健一💟💘💙ྀི913🐶🐠🦐
on 17.live
Viewers: 8
Duration: 599 min. -
3884
 용희(yonghee)
on bigo.tv
용희(yonghee)
on bigo.tv
Viewers: 8
Duration: 14 min. -
3885
 AceeOfClubz
on twitch.tv
AceeOfClubz
on twitch.tv
Viewers: 8
Duration: 6 min. -
3886
 oneida_dhakal
on tiktok.com
oneida_dhakal
on tiktok.com
Viewers: 8 -
3887
 SirSmokesAlottt
on kick.com
SirSmokesAlottt
on kick.com
Viewers: 8
Duration: 11 min. -
3888
 PieZet
on kick.com
PieZet
on kick.com
Viewers: 8
Duration: 9 min. -
3889
 WildeClub
on kick.com
WildeClub
on kick.com
Viewers: 8
Duration: 11 min. -
3890
Трансляции служб. Свято-Eлисаветинский монастырь on vk.com
Viewers: 8
Duration: 49 min. -
3891
 Adeline_Scarfpaw
on twitch.tv
Adeline_Scarfpaw
on twitch.tv
Viewers: 8
Duration: 107 min. -
3892
 TanyaBelkova
on vk.com
TanyaBelkova
on vk.com
Viewers: 8
Duration: 569 min. -
3893
 PRO_NHL
on vk.com
PRO_NHL
on vk.com
Viewers: 8
Duration: 105 min. -
3894
 NBA | НБА Прямые трансляции | SPORTDRIVER
on vk.com
NBA | НБА Прямые трансляции | SPORTDRIVER
on vk.com
Viewers: 8
Duration: 105 min. -
3895
 horseliro
on twitch.tv
horseliro
on twitch.tv
Viewers: 7
Duration: 1 min. -
3896
 luckpb
on twitch.tv
luckpb
on twitch.tv
Viewers: 7
Duration: 284 min. -
3897
 GHOULNOLIFE
on twitch.tv
GHOULNOLIFE
on twitch.tv
Viewers: 7
Duration: 64 min. -
3898
 Azularada
on twitch.tv
Azularada
on twitch.tv
Viewers: 7
Duration: 15 min. -
3899
 Warley_Alves
on twitch.tv
Warley_Alves
on twitch.tv
Viewers: 7
Duration: 64 min. -
3900
 erl4nzera1st_
on twitch.tv
erl4nzera1st_
on twitch.tv
Viewers: 7
Duration: 64 min.

